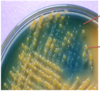
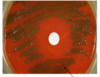
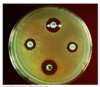

Becky Wright - bacteria Flashcards
(88 cards)
Describe the Gram-staining process steps and outcomes:
Heat fixed cells
1) Crystal violet (violet gram positive)
2) Iodide added (binds to Crystal violet and traps large complexes in gram positive cells)
3) Ethyl alcohol (decolourises gram negative, removing its outer lipopolysaccharide layer, exposing thin peptidoglycan layer, which liberates CV-I complexes)
4) Safranin counterstain (pink for gram negative)

Blood agar, chocolate agar. What are they and what’s the difference?
Enriched nutrient agars,
Chocolate agar’s blood cells are heated to lyse them, allowing the growth of fastidious (picky) respiratory bacteria like Haemophilus influenzae and Neisseria meningitidis
How might you differentiate Staphylococcus aureus from other aerobic gram positive bacteria using 2 tests?
(any other tests?)
Catalase positive (vs Streptococci)
Coagulase positive (vs other Staphylococci species)
[MSA selective medium: salt and mannitol **fermentation **–> yellow]
[haemolytic –> golden cluster colonies on blood agar]
[DNAase positive, clears around colonies]
POSITIVE FOR EVERYTHING
3 Skin infections caused by Staph.aureus?
(a gram positive coccus)
Furunculosis/Folliculitis (boils)
Impetigo (rupturing pustules –> crusty, infectious)
Cellulitis (subcutaneous tissue infection)
NOT necrotising fasciitis (Strep pyogenes does that)
Describe some of the virulence factors of Staphylococcus aureus:
Adhesion factors: variety of MSCRAMMS
Enzymes: Lipases etc digest host tissue, coagulase forms fibrin coat
Protein A: binds Ab Fc portion
Exotoxin: PVL often in MRSA
Exotoxins: Staphylococcus Enterotoxins, SEs (A-E,G-J)
Exotoxin: TSST-1 Superantigen (toxic shock syndrome)

Streptococcus pyogenes classification methods?
Gram positive cocci (in chains)
Grown on blood agar (won’t grow on nutrient agar like Staph.aureus can) **Beta-haemolytic **yellow colonies
Catalase negative (unlike S.aureus)
Lancefield group A (Group A strep) (antibodies to specific group carbohydrates in the cell walls)
Diseases caused by Streptococcus pyogenes?
Skin/soft tissue infections like Impetigo, Cellulitis, Necrotising fasciitis
Strep. throat, tonsilitis, Scarlet fever (rash and fever typically in children)
Toxic shock syndrome, bacteraemias etc..
Noninfectious sequelae like Rheumatic fever or acute glomerulonephritis
Streptococcus pyogenes virulence factors?
Adhesion factors: Surface F protein. Lipoteichoic acid LTA (a Gram +ve cell wall component) binds fibronectin.
_Immune evasion: _**M protein **(variable) binds host proteins, destabilises complement, bind fibrinogen (activating neutrophils)
Poorly immunogenic capsule.
C5a peptidase degrades complement.
Enzymes: **Streptokinase! **Fibrinolytic. Activates plasminogen.
Hyaluronidase (digests ECM component, carbon source and invasion?)
_Exotoxins: _**Pyrogenic, **strain specific, SPE: A/B/C
Non-infectious sequelae of Streptococcus pyogenes infection?
Autoimmune damage mediated:
Rheumatic fever: Joint and heart valve inflammation and damage. Normally associated with pharyngitis and specific M proteins.
Acute glomerulonephritis AGN: Different strain
Define diarrhoea, dysentery, food poisoning, and gastroenteritis:
Diarrhoea = change in frequency or consistency of stools
Dysentery = blood and mucus in faeces (from inflammation), diarrhoea, abdominal pain
**Gastroenteritis = **nausea, vomiting, diarrhoea
Food poisoning = gastroenteritis symptoms associated with a particular food source
What is MacConkey agar?
and what is SMAC for?
MacConkey agar is selective agar for gram negative bacteria (such as E.coli)
It contains bile salts to inhibit Gram positives, and neutral red pH indicator that turns pink if colony ferments lactose
[Sorbitol MacConkey agar is selective for enteropathogenic E.coli strain O157:H7. Lactose replaced with sorbitol. Salmonella and shigellas can’t ferment lactose, and this pathogenic strain of E.coli can’t ferment sorbitol (unlike other non-pathogenic strains)–> colourless colonies.]

What are serotypes? serogroups?
(pathotypes and strains?)
The serotypes of bacterial cells are their classification by different surface antigens. Serogroups are groups of serotypes with some of the same antigens.
Strains can be often recognised by their serotypes.
Different pathotypes cause different patterns of infections because they produce different virulence factors. Specific serotypes can be associated with specific syndromes.
(EHEC pathotype often has serotype: O157:H7 associated with HUS)
O = somatic, cross species. H = flagellar antigen, more specific

Enterotoxigenic ET E.coli?
Pathophysiology and symptoms
Causes travellers diarrhoea (ET was a traveller?)
Virulence factors: Adhesins = colonisation factor antigens (CFAs)
Enterotoxins –> diarrhoea
Heat-stable toxin (ST) –> cGMP –> fluid secretion
Heat-labile toxin (LT) –> cAMP –> chloride and fluid secretion
(stable like the Ground, labile like the Air)

Enteropathogenic, EP, E.coli, EPEC?
Pathophysiology and symptoms?
Diarrhoea in children under 2yo!
- Pathogenicity island contains LEE (locus for enterocyte effacement)
- Encodes a Type III secretion system T3SS/injectosome!
- A needle-like structure that inserts Tir into host cell
- Intimin binds Tir (attachment)
- Causes diarrhoea by effacement of microvilli, effacing lesion caused by attachment

Enterohaemorrhagic E.coli EHEC? (and STEC, VTEC)
Pathophysiology and Symptoms?
Source of infection, reservoir?
Commonly serotype O157:H7
Different names: STEC =shiga-like toxin producing e.coli
VTEC = verocytotoxin (shiga-like) producing e.coli
Can lead to bloody diarrhoea and even HUS
Adhesion like EPEC.
Toxins encoded by bacteriophage Stx phage.
Release caused by phage mediated lysis in response to stress! therefore don’t treat with Abx
Source of infection = contaminated food
Reservoir = cattle
Shiga toxin Stx, mode of action?
Binds Globotriaosylceramides Gb3s
on Paneth (goblet) cells in intestine, and kidney epithelial cells.
Inhibit protein synthesis by disrupting ribosomes
What is special about EaggEC in the german outbreak?
Serotype O104:H4
EaggEC with shiga toxin producing capability.
Higher number of cases of HUS, possibly due to better adhesion (aggregation of cells on top of each other) and so better uptake of toxin?
How to screen and diagnose EHEC?
[Diarrhoea only diagnosed when severe, persistant or with HUS]
SMAC (sorbitol-MacConkey agar) colourless colonies (non-sorbitol fermenting, unlike normal flora)
Follow up this screen with PCR for shiga-like toxin and serotyping (serology)
Common causes of travellers diarrhoea?
ETEC and EAggEC most cases but typically not diagnosed
Most diagnosed cases are Salmonella, Shigella and Campylobacter
Compare and Contrast E.coli and Salmonella:
Both** **Gram negative bacilli, facultative anaerobes that grow on unenriched media
Both oxidase negative
Both possess O and H antigens
But: E.coli ferments lactose whilst salmonella doesn’t
Salmonella produces H2S (hydrogen sulfide)
4 Salmonella *enterica *subspecies and their 2 diseases:
Salmonella Typhi and Paratyphi cause Enteric/Typhoid fever
Salmonella Typhimurium and Enteritidis cause gastroenteritis
Salmonella gastroenteritis epidemiology and pathophysiology?
Reservoir: GI tracts of birds (poultry), domestic animals, reptiles
Source of infection: heavily contaminated food, esp. poultry
Pathophys: Attachment by T3SS in small intestine
Triggers endocytosis, multiplies in vesicle, kills host cell inducing fever, pain and diarrhoea
TLR4 recognition –>cytokines–>neutrophil migration

Salmonella *enterica *Typhoid fever (Typhi or Paratyphi)
Epidemiology and Pathophysiology?
Epidemiology: Reservoir = human, case or carrier (e.g. in gall bladder intracellular or gallstone biofilm)
Source of infection mode of transmission: ingestion of contaminated food
Pathophysiology: SPI7 (salmonella pathogenecity island 7) Helps export of Vi capsular antigen, capsule –> evades TLR4
SPI7 Encodes Tvi regulatory protein that inhibits flagellin, normally recognised by TLR5 –> evades
Enters macrophages –> lymph nodes –> blood –> liver,spleen,BM,gall bladder –>blood –>other tissues
Contrast management of Salmonella Typhi and Typhimurium: Typhoid fever vs gastoenteritis
Typhoid fever –> blood sample. Abx. Quarantine. Source control. Gall bladder removal in carriers?
Gastroenteritis –> stool sample. no Abx (self-limiting), source control